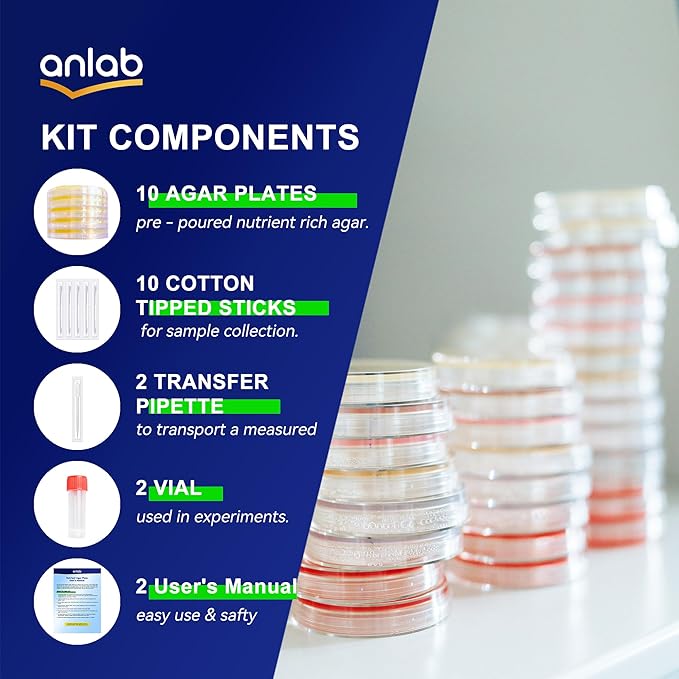
Nutrient Agar Petri Dishes Science Project Kit | Pre-Poured Agar Plates and Cotton Swabs for Science Experiments | Bacteria Science Kit - Sealed Separately (Items of 60)
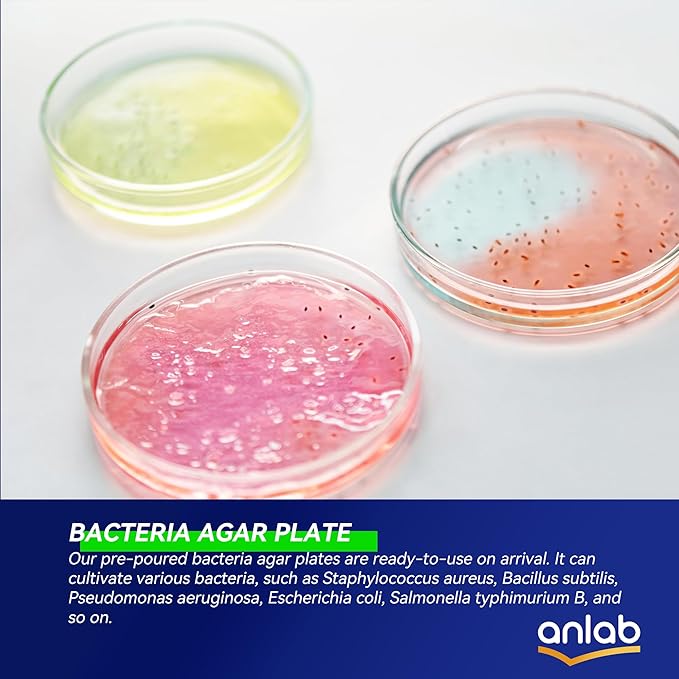
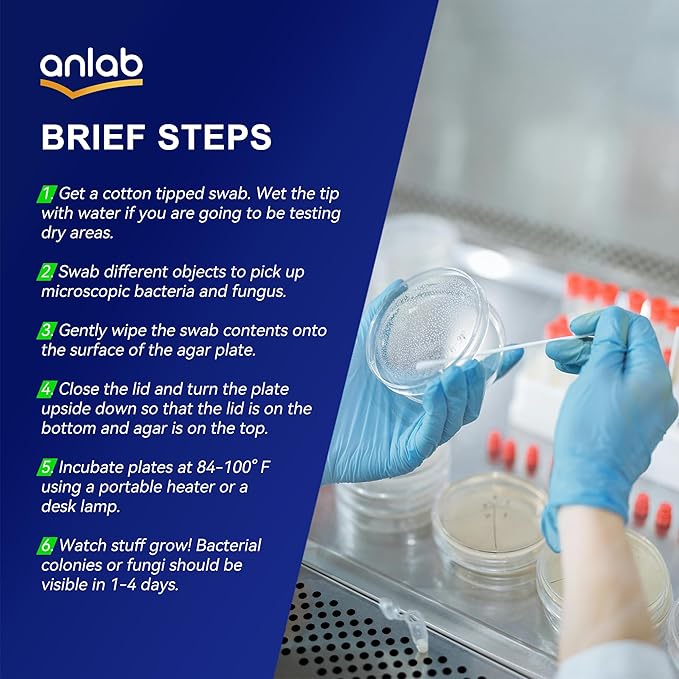
Nutrient Agar Petri Dishes Science Project Kit | Pre-Poured Agar Plates and Cotton Swabs for Science Experiments | Bacteria Science Kit - Sealed Separately (Items of 60)
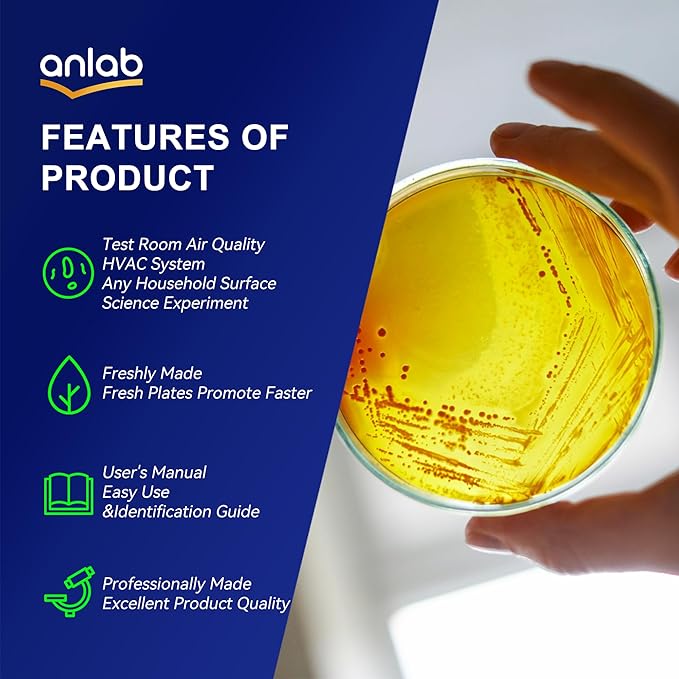
Nutrient Agar Petri Dishes Science Project Kit | Pre-Poured Agar Plates and Cotton Swabs for Science Experiments | Bacteria Science Kit - Sealed Separately (Items of 60)

Safetyisatanlab
Nutrient Agar Petri Dishes Science Project Kit | Pre-Poured Agar Plates and Cotton Swabs for Science Experiments | Bacteria Science Kit - Sealed Separately (Items of 60)
Nutrient Agar Petri Dishes Science Project Kit | Pre-Poured Agar Plates and Cotton Swabs for Science Experiments | Bacteria Science Kit - Sealed Separately (Items of 60)
Couldn't load pickup availability
About This
- 🐯 OUR DIFFERENCES: anlab's products are individually sealed. With each plate & cotton swab having a separate sealed packaging. This way, you can open a certain plate according to your own arrangement, while other plates are completely unaffected. Other brands' products are sealed together in multiple containers, so once the packaging is opened, all the plates must be used up, otherwise the products will soon expire and become ineffective.
- 🦁 THE COMPLETE SCIENCE KIT: Start your science experiment journey with our kit, complete with 60 pre-poured agar plates, 60 cotton tipped sticks, 12 pipette, 12 plastic vial to be used in experiments, simple-to-follow instructions.
- 🦊 SCIENCE EXPERIMENTS PROJECT TOOLS: This petri dish with agar is a great agar choice for science fair and classroom projects, Extract Agar can be used for science fair projects or classroom experiments because it cultures a wide variety of and is safe to use.
- 🐮 DIY MOLD TESTING: If you are concerned about mold in your house, you can take a sample and add it to these plates to test for mold. However, it is not possible to determine the type of them.
- 🐶 PURCHASE TIPS: The plate in good condition! We will try to get you 10 extraction agar plates. If the agar you receive is melted, please put the refrigerator for half an hour before using it. If the board is damaged in any way or you are not satisfied for any reason, we will replace it, no questions asked.
Share







you may also like
-
260 PCS Pop Keychain Bulk Party Favors,Fidget Toys for Kids Bulk Mini Pop Keychain Sensory Toys Stocking Pinata Stuffers Birthday Classroom Prizes Toddler Fidget Pack Stress Relief Toys
Regular price $38.99 USDRegular price $38.99 USDUnit price / per -
Fidget Cube New Version Fidget Finger Toys - Metal Infinity Cube Prime for Stress and Anxiety Relief/ADHD, Ultra Durable Sensory Gifts for Adults and Teens Kids
Regular price $32.99 USDRegular price $32.99 USDUnit price / per -
3PC Magnetic Silent Fidget Toys Sensory Toys for Kids with Autism,Fidget for Classroom Must Haves,Magnetic Flip Slider Anxiety Relief Items for ADHD Classroom Treasure Box Toys & Stocking Stuffers
Regular price $14.99 USDRegular price $14.99 USDUnit price / per -
8 Pack Sensory Toys for Kids with Autism, Fidget Toys Adults Calming, Sensory Stickers for Anxiety Relief Items, Fidget Strips for Classroom Desk, Party Favors Valentine Classroom Gifts for Travel
Regular price $11.99 USDRegular price $11.99 USDUnit price / per
Collections
-

Solid Feeding
Discover the Solid Feeding collection at Sweet Nest, where thoughtful design meets...
-

Bottle-Feeding
Discover the perfect blend of comfort and functionality with Sweet Nest’s Bottle-Feeding...
Blog posts
View all-

Sensory Exploration Toys: Why They Matter and H...
Sensory exploration toys help children explore through touch, regulate emotions, and engage calmly during indoor play.
Sensory Exploration Toys: Why They Matter and H...
Sensory exploration toys help children explore through touch, regulate emotions, and engage calmly during indoor play.
-

Winter Indoor Play Toys: How to Choose the Righ...
A practical guide to choosing winter indoor play toys that support balance, focus, and independent play when kids can’t go outside.
Winter Indoor Play Toys: How to Choose the Righ...
A practical guide to choosing winter indoor play toys that support balance, focus, and independent play when kids can’t go outside.
-

Third-trimester sleep routine tips
Practical, calming sleep routine tips for the third trimester—pillows, temperature cues, slow-down rituals, and small habits that help you rest better.
Third-trimester sleep routine tips
Practical, calming sleep routine tips for the third trimester—pillows, temperature cues, slow-down rituals, and small habits that help you rest better.
Frequently Asked Question

What is the return policy?
Our goal is for every customer to be totally satisfied with their purchase. If this isn’t the case, let us know and we’ll do our best to work with you to make it right
Are any purchases final sale?
We are unable to accept returns on certain items. These will be carefully marked before purchase.
When will I get my order?
We will work quickly to ship your order as soon as possible. Once your order has shipped, you will receive an email with further information. Delivery times vary depending on your location.
Where are your products manufactured?
Our products are manufactured both locally and globally. We carefully select our manufacturing partners to ensure our products are high quality and a fair value.